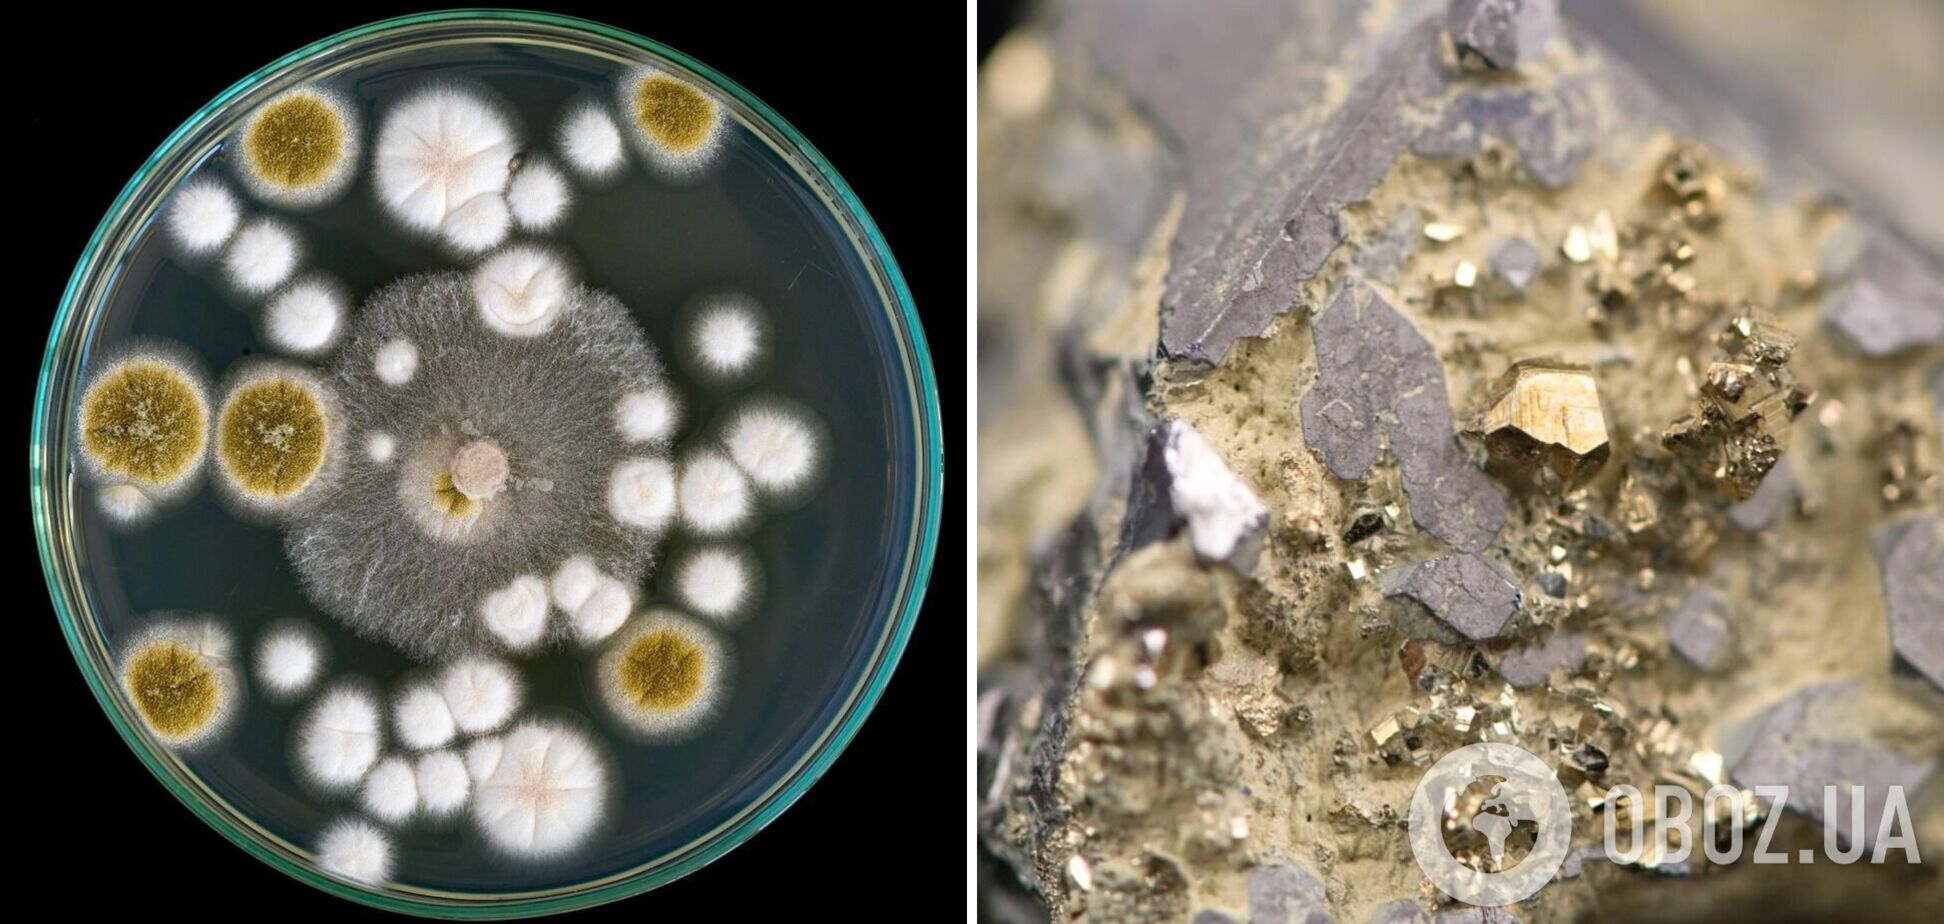
В Австралии обнаружили грибы, которые могут питаться золотом: в чем уникальность открытия

В Австралии обнаружили грибы, которые могут питаться золотом: в чем уникальность открытия
Австралийские ученые выяснили, что выделенные из аэробного гранулированного ила грибки XY3 (которые имеют 99% сходства со штаммом Candida rugopelliculosa), производят золотые наночастицы AuNP. Это происходит в результате реакции на стресс при условии воздействия на грибок определенных соединений золота.
Группа экспертов из Государственного объединения научных и прикладных исследований CSIRO (Австралия) опубликовала результаты в журнале Heliyon. Ученые надеются, что открытие грибка, "питающегося" золотом, может произвести революцию в поиске металлов и минералов не только на Земле, но и на астероидах и других планетах.
Грибки XY3 реагируют на золотые частицы в почве, после чего вырабатывают золотые наночастицы AuNP. Их обнаружили на мицелии – тонких "нитях", которые помогают грибкам поглощать питательные вещества.
Это открытие вызывает удивление, поскольку золото редко вступает в реакции с живыми организмами. Грибки, по-видимому, способны взаимодействовать с золотом посредством процессов своего метаболизма.
"Золото настолько химически неактивно, что этот тип взаимодействия необычен и удивителен", – отметил доктор Цин Боху, ведущий исследователь CSIRO.
Он и его команда заметили, что XY3 растут быстрее и выглядят более здоровыми, когда к их клеткам прикрепляется золото.
Некоторые эксперты полагают, что эти результаты могут помочь геологам в поисках подземных месторождений золота.
Традиционно геологоразведочные компании анализировали растения, почвы и даже воду, чтобы обнаружить богатые золотом районы, но использование грибков, реагирующих на этот драгоценный метал, потенциально более экологичный вариант, чем обширные раскопки. Что еще важнее, использование возможностей живого организма означает, что золото можно будет собирать в формах, которые легче очищать без применения едкой химии и большого количества воды.
Ученые предполагают, что некоторые грибки, такие как XY3, выделяют особые полисахариды и белки, которые восстанавливают ионы металлов и сохраняют полученное золото в стабильной форме наночастиц.
В то время как космические агентства и частные компании уже изучают методы добычи ресурсов на астероидах, способность грибка перерабатывать золото в суровых условиях имеет потенциал для внеземного применения.
Инженеры спорят, насколько хорошо грибок будет себя вести в условиях низкой гравитации с ограниченным количеством питательных веществ. Однако концепция отправки живых систем в космос для работы с сырьем интригует тех, кто хочет снизить стоимость миссий.
Если грибок сможет размножаться и перерабатывать металлы с использованием минимального оборудования, это может изменить то, как организации готовятся к добыче ресурсов вдали от Земли.
Как ранее писал OBOZ.UA, последние 20 лет Американское аэрокосмическое агентство NASA по заказу правительства США ищет вблизи Земли потенциально опасные астероиды. Это те небесные тела, которые вращаются вокруг Солнца и приближаются к нашей планете на расстояние 1,3 астрономических единиц. Недавно вероятную угрозу нашли и вблизи Венеры.
Только проверенная информация у нас в Telegram-канале OBOZ.UA и в Viber. Не ведитесь на фейки!











